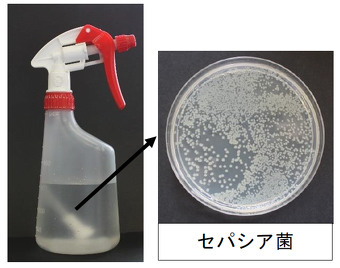

トリガータイプのスプレーポンプ(ノズル部分)は、洗浄や乾燥が行いにくいので、微生物汚染を受けやすいです。図には緑茶およびベンザルコニウム塩化物(低水準消毒薬)の細菌汚染例を示しましたが、おもな汚染原因はノズル部分の汚染と推定されました。しかし、中水準消毒薬である消毒用エタノールの場合では、細菌芽胞を除いて汚染を受けることはありません。ゴミやホコリなどとともにバチルス属などの芽胞が少量混入することはあっても、増殖することはありません。したがって、消毒用エタノールの場合では、スプレーポンプの交換の目安を6か月毎などとして差し支えないでしょう。
なお、一般論ですが、消毒薬の噴霧は清拭に比べて消毒効果が大幅に低下します1,2)。噴霧では消毒対象全面に消毒薬が接触する訳ではありませんし、拭き取り効果も期待できないからです。また、次亜塩素酸ナトリウムやベンザルコニウム塩化物などの噴霧では、喘息などの曝露毒性が問題になることが分かっています3-7)。さらに、1998年に改正された感染症法では、消毒薬の噴霧は推奨されていません8)。したがって、消毒用エタノールであっても、噴霧使用は望ましくありません。
ただし、ご質問者が行っておられるような清拭用としての散布は問題ありません。
図.トリガータイプのスプレーボトル液の細菌汚染例
左;7日間にわたりつぎ足し使用していた緑茶,右;2か月間にわたりつぎ足し使用していた0.02%ベンザルコニウム塩化物
引用文献
- Bolton SL, Kotwal G, Harrison MA, et al. Sanitizer efficacy against murine norovirus, a surrogate for human norovirus, on stainless steel surfaces when using three application methods. Appl Environ Microbiol 2013; 79: 1368-1377.
- Panousi MN, Williams GJ, Girdlestone S, et al. Evaluation of alcohol wipes used during aseptic manufacturing. Lett Appl Microbiol 2009; 48: 648-651.
- Holm SM, Leonard V, Durrani T, et al. Do we know how best to disinfect child care sites in the United States? A review of available disinfectant efficacy data and health risks of the major disinfectant classes. Am J Infect Control 2019; 47: 82-91.
- Daschner F, Schuster A. Disinfection and the prevention of infectious disease: no adverse effects? Am J Infect Control 2004; 32: 224-225.
- Sherriff A, Farrow A, Golding J, et al. Frequent use of chemical household products is associated with persistent wheezing in pre-school age children. Thorax 2005; 60: 45-49.
- Casas L, Zock JP, Carsin AE, et al. The use of household cleaning products during pregnancy and lower respiratory tract infections and wheezing during early life. Int J Public Health 2013; 58: 757-764.
- Casas L, Espinosa A, Borràs-Santos A, et al. Domestic use of bleach and infections in children: a multicentre cross-sectional study. Occup Environ Med 2015; 72: 602-604.
- 大久保 憲,尾家重治,金光敬二.2025年版 消毒と滅菌のガイドライン.へるす出版.
尾家 重治(山陽小野田市立 山口東京理科大学 薬学部)
2025年06月